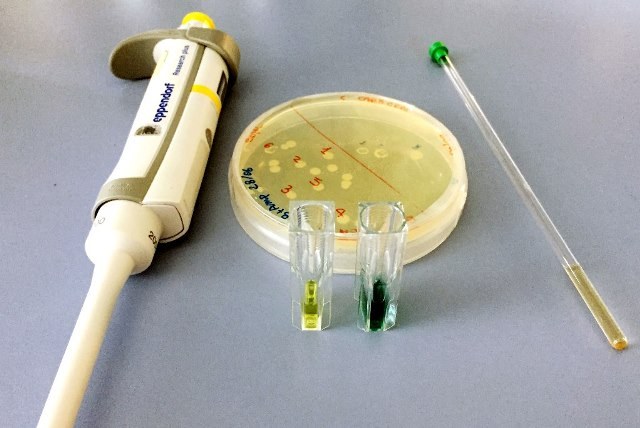
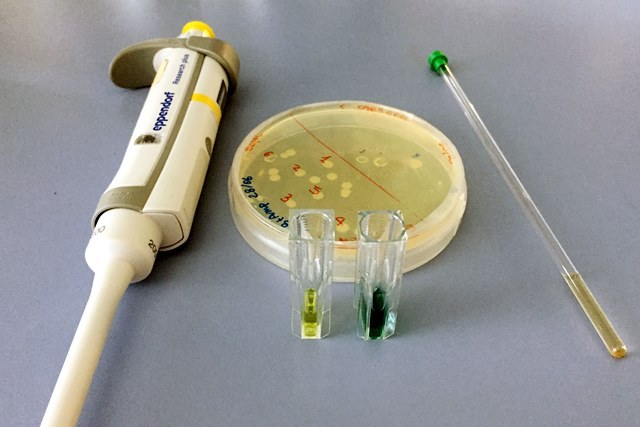

La vita cellulare ha bisogno di disordine: alcuni enzimi riescono a svolgere correttamente le loro funzioni solo mantenendosi flessibili. E per farlo devono conservare una struttura disordinata. Sono le conclusioni – appena pubblicate sulla rivista Scientific Reports – di uno studio condotto da ricercatori del Dipartimento di Farmacia e Biotecnologie (FaBiT) dell’Università di Bologna, in collaborazione con il CNRS di Marsiglia.
Oggetto della ricerca è UreG, un enzima responsabile della regolazione dell’ureasi, proteina batterica che determina la capacità infettiva di alcuni patogeni, ad esempio Helicobacter pylori, il batterio dell’ulcera.
Già in passato, i ricercatori del FaBiT avevano dimostrato che UreG non ha una struttura univoca, ma fluttua di continuo in un insieme di conformazioni diverse. Ora, invece, hanno studiato cosa succede quando questa flessibilità è alterata aggiungendo alcune molecole capaci di irrigidire la struttura delle proteine. I risultati – misurati combinando tecniche spettroscopiche e saggi funzionali – hanno dimostrato che l’enzima deve mantenere la sua mobilità strutturale per rimanere attivo.
“I dati ottenuti – spiega Barbara Zambelli, ricercatrice Unibo che ha coordinato l’indagine – dimostrano non solo che l’enzima che stiamo studiando funziona in assenza di una struttura tridimensionale ben definita, ma anche che, se lo si costringe in una struttura tridimensionale troppo rigida, questo perde totalmente la sua attività”.
In passato, il funzionamento delle proteine era esemplificato dal “modello chiave-serratura”, secondo cui ogni proteina può interagire attraverso la sua struttura tridimensionale rigida con il suo partner complementare, in un’interazione biunivoca. Questa visione, però, è stata messa in crisi negli ultimi quindici anni dalla scoperta di un numero sempre crescente di proteine che funzionano in assenza di una struttura ben definita.
“Si chiamano proteine intrinsecamente disordinate – spiega Elisabetta Mileo del CNRS di Marsiglia, l’altra autrice dello studio – e funzionano come serrature che possono essere aperte da tante chiavi diverse, e la cui forma dipende dalla chiave inserita”. Gli enzimi però – catalizzatori biologici fondamentali per i processi vitali – sono stati a lungo considerati come eccezioni a questa idea di interazioni molecolari flessibili. “Oggi sappiamo – continua Zambelli – che alcuni enzimi richiedono lo stesso disordine strutturale, e questo sta cambiando la visione struttura-centrica del loro meccanismo catalitico”.
Un cambiamento di prospettiva che può portare a ricadute importanti sul futuro della ricerca farmaceutica. “Gli studi di drug-design – conclude Zambelli – si basano spesso su una visione rigida dell’interazione farmaco-recettore. Ma il nostro studio suggerisce che l’inibizione funzionale possa sfruttare anche l’arresto della mobilità dei target enzimatici”.